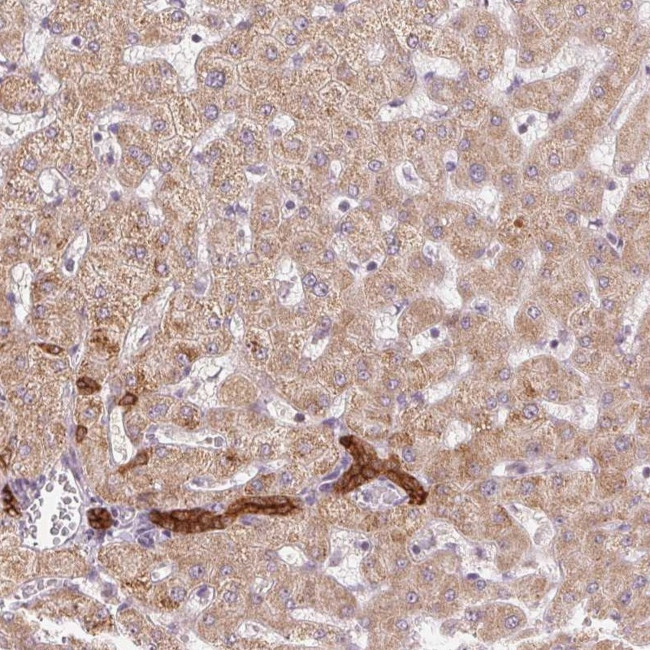
ARHGAP32 Antibody in Immunohistochemistry (Paraffin) (IHC (P))

Search
Invitrogen
ARHGAP32 Polyclonal Antibody
{{$productOrderCtrl.translations['antibody.pdp.commerceCard.promotion.promotions']}}
{{$productOrderCtrl.translations['antibody.pdp.commerceCard.promotion.viewpromo']}}
{{$productOrderCtrl.translations['antibody.pdp.commerceCard.promotion.promocode']}}: {{promo.promoCode}} {{promo.promoTitle}} {{promo.promoDescription}}. {{$productOrderCtrl.translations['antibody.pdp.commerceCard.promotion.learnmore']}}

Please note: We are reviewing Western blot images included in the antibody testing data in our catalog, including those provided by third parties. Unless expressly labeled or annotated as “raw-unedited”, Western blot images included in the antibody testing data in our catalog may have been edited, optimized or otherwise adjusted for presentation.
产品信息
PA5-63970
种属反应
宿主/亚型
分类
类型
抗原
偶联物
形式
浓度
规格
纯化类型
保存液
内含物
保存条件
运输条件
RRID
产品详细信息
Immunogen sequence: PNDHNVVSMP PAADVKHTYT SWDLEDMEKY RMQSIRRESR ARQKVKGPVM SQYDNMTPAV QDDLGGIYVI HLRSKSDPGK TGLLSVAEGK
Highest antigen sequence identity to the following orthologs: Mouse - 93%, Rat - 94%.
靶标信息
GTPase-activating protein (GAP) promoting GTP hydrolysis on RHOA, CDC42 and RAC1 small GTPases. May be involved in the differentiation of neuronal cells during the formation of neurite extensions. Involved in NMDA receptor activity-dependent actin reorganization in dendritic spines. May mediate cross-talks between Ras- and Rho regulated signaling pathways in cell growth regulation. Isoform 2 has higher GAP activity.
仅用于科研。不用于诊断过程。未经明确授权不得转售。
篇参考文献 (0)
生物信息学
蛋白别名: Brain-specific Rho GTPase-activating protein; GAB-associated Cdc42/Rac GTPase-activating protein; GC-GAP; GTPase regulator interacting with TrkA; p200RhoGAP; p250GAP; Rho GTPase-activating protein 32; Rho-type GTPase-activating protein 32; Rho/Cdc42/Rac GTPase-activating protein RICS; RhoGAP involved in the beta-catenin-N-cadherin and NMDA receptor signaling
基因别名: ARHGAP32; GRIT; KIAA0712; RICS
Entrez Gene ID: (Human) 9743